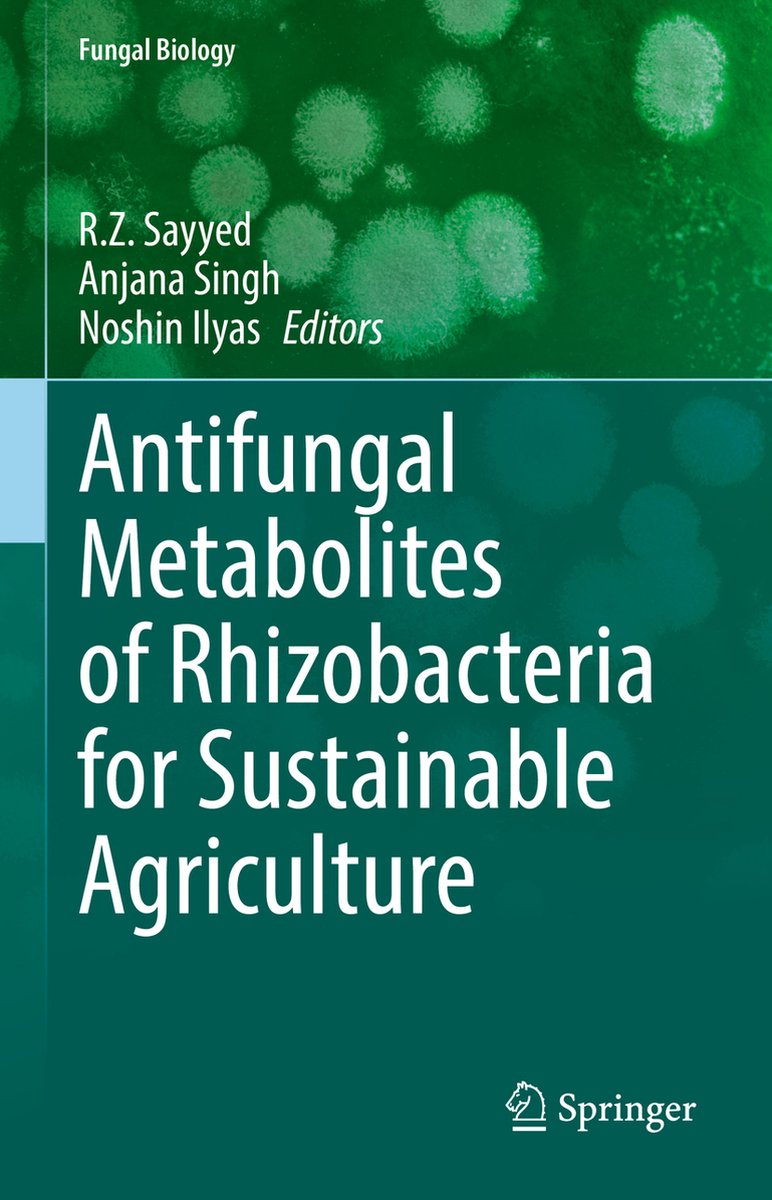

Functional Food Carbohydrates
Bekijk boek
We hebben 792 boeken gevonden met de eerste letters fun
Nieuw (2)
vanaf € 105,00
vanaf € 105,00
Nieuw (2)
vanaf € 73,59
vanaf € 73,59
Nieuw (2)
vanaf € 189,00
vanaf € 189,00
Nieuw (2)
vanaf € 92,99
vanaf € 92,99
Nieuw (2)
vanaf € 15,00
vanaf € 15,00
Nieuw (2)
vanaf € 145,00
vanaf € 145,00
Nieuw (2)
vanaf € 155,00
vanaf € 155,00
Nieuw (2)
vanaf € 169,00
vanaf € 169,00